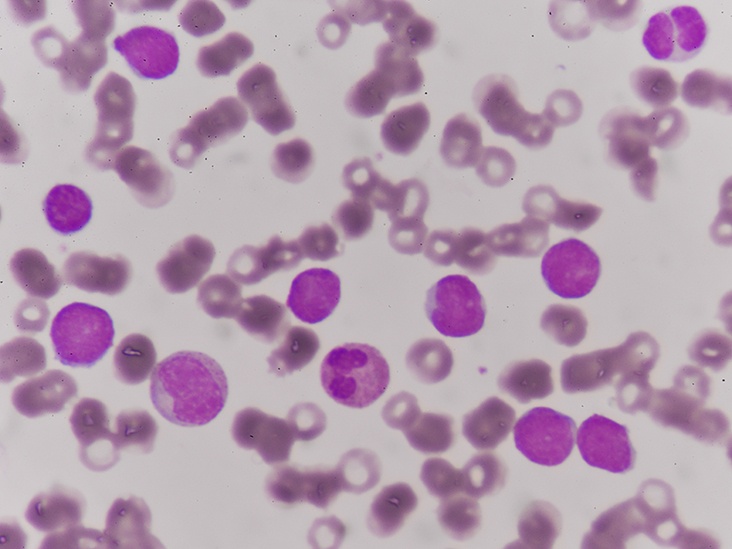

Заболевания
Фонд борьбы с лейкемией запускает информационный портал для людей с раком крови

Ответить
Заболевания
Главная » Заболевания » Фонд борьбы с лейкемией запускает информационный портал для людей с раком крови
Портал #СамоеВремяЖить станет первой в России виртуальной библиотекой знаний об онкологических заболеваниях кроветворной системы. Он позволит пациентам и их близким получать актуальную и достоверную информацию о диагнозах, способах и методах лечения, предоставит возможность общения с равными консультантами и психологами, а также станет площадкой для обсуждения личного опыта и диалога с другими пользователями ресурса.
На сегодняшний день рак крови по-прежнему воспринимается большинством россиян, как смертельный приговор, а непонимание, как помочь близкому человеку, вызывает панику и отчаяние у его родных. Люди очень нуждаются в качественной и систематизированной информации, которая позволила бы им правильно оценивать ситуацию, грамотно выстраивать коммуникацию с врачами и другими специалистами, а также получать различную помощь и поддержку.
Именно для этого Фонд борьбы с лейкемией создал специализированный портал #СамоеВремяЖить – единый информационный источник о злокачественных заболеваниях крови и связанных с ним проблемах.
Анастасия Кафланова, директор Фонда борьбы с лейкемией:
«Когда человек узнаёт о своей болезни, то первым делом пытается найти о ней информацию в Интернете. Но довольно часто эта информация в лучшем случае бесполезна, в худшем – опасна для того, кто пока не очень хорошо разбирается в проблеме. Поэтому мы поставили перед собой довольно амбициозную задачу – систематизировать знания об онкогематологических заболеваниях и сделать специальный ресурс с достоверной и актуальной информацией. Все материалы портала верифицируются ведущими специалистами страны, и, безусловно, помогут людям лучше понять свой диагноз, настроиться на лечение и поверить в то, что рак – не приговор».
Разделы портала откроют пациентам и их близким доступ к информации о современных методах лечения рака крови, общению с ведущими гематологами и врачами смежных специальностей, предоставят возможность получить психологическую поддержку или помощь равного консультанта, а также обсудить свою проблему с другими пользователями в специальном чате.
Проект реализуется при поддержке Фонда президентских грантов.
Статьи от экспертов о здоровом образе жизни, семейных отношениях, болезнях, красоте и др. Советы экспертов по фитнесу, диетам, правильному питанию.Справочники.
Odnoklassniki
VKontakte
Telegram
RSS